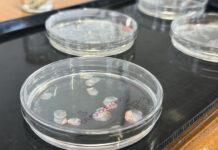
Córneas artificiales hechas de escamas de pescado: cómo este desarrollo podría transformar los trasplantes oculares

El glaciar ‘Okjökull’ es sólo el primero de muchos, pues de acuerdo con las investigaciones, se espera que todos los glaciares que caracterizan la isla se derritan antes del 2200.
La placa titulada “Una carta al futuro”, señala que ‘Ok’ fue el primer glaciar islandés en derretirse y que en los próximos 200 años, se espera el mismo destino para todos ellos.
La placa de metal se instalará el 18 de agosto en un fiordo al este de la isla y espera servir como llamado de atención sobre el riesgo que significa la desaparición de los glaciares, al ser las reservas de agua dulce más grandes de la Tierra.
El derretimiento de los polos, y con ello los glaciares, ha sido una de las principales señales de alerta sobre el cambio climático y el calentamiento global.
El norte es una de las zonas más afectadas por el incremento de dióxido de carbono en la atmósfera, calentándose en promedio dos veces más rápido que el resto del mundo.
Fuente: SDP Noticias